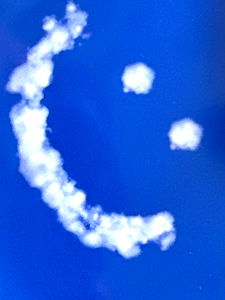
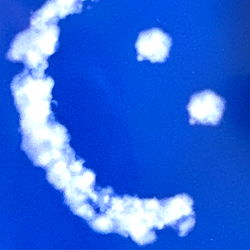
Ruby Roses photo

Kenna ๐ฆ
Ruby Roses: Your Go-To Source for Free Content
Ruby Roses

Ruby Roses is a 3D animated model of an adult woman with long brown hair and red clothing. She stands in what appears to be a cozy bar setting, with her arms crossed confidently. The model is designed with high-quality textures and features realistic lighting effects that enhance its lifelike appearance.
Welcome to the world of Ruby Roses! A young and vivacious creator who has brought her unique blend of talent directly to your fingertips through OnlyFans. With a commitment to providing nothing but top-notch entertainment at absolutely no cost, she is the epitome of what it means to be an artist dedicated to her audience.
Ruby Roses' presence on OnlyFans began on July 19th, 2024. Since then, she has been consistently releasing content that includes a total of three posts, five photos, and one video. With the addition of six pieces of media in total, her profile offers an impressive array of visual and audio delights.
As you browse through Ruby Roses' catalogue, expect to find personalized content tailored just for you. Her dedication lies in not only presenting a vast amount of free content but also ensuring that each piece is engaging, unique, and adds value to your experience on OnlyFans.
Ruby Roses has been meticulously verified by the platform, which guarantees authenticity and quality control standards are met. No need for concern about subscription fees either; she believes in sharing her art with her fans without any barriers or costs.
Unleash Exclusive Content with Ruby Roses on OnlyFans
Are you ready for an immersive experience that promises captivating entertainment tailored just for you? Ruby Roses, a shining star in the OnlyFans community, offers her unique blend of artistic talent exclusively to her followers. Subscribe to her profile now and unlock access to personalized content that is specifically created with your interests in mind.
By subscribing to Ruby Roses' OnlyFans page, you become part of an exclusive family where every piece of content holds personal significance. Ruby's dedication lies not only in bringing top-quality entertainment but also in fostering strong connections with her audience through personalized content that leaves a lasting impression.
The journey of Ruby Roses on OnlyFans began on July 19th, 2024, marking the start of an incredible adventure filled with creativity and innovation. With her verified account, you can trust that every piece of content she shares adheres to the highest standards of quality control.
Expect to find a rich collection of posts, photos, videos, and additional media totaling six pieces. Ruby's personalized offerings ensure that each interaction is unique, engaging, and adds true value to your OnlyFans experience.
In addition to her impressive content, you'll also enjoy the convenience of an ad-free subscription process. No need to worry about hidden costs or commitment; Ruby Roses believes in sharing her art with her fans without any barriers or financial burdens.
Should you ever have questions about Ruby's profile, know that she is just a message away. As a subscriber, you gain the opportunity to connect directly with Ruby herself through private messaging, fostering an environment where your feedback and preferences are genuinely appreciated and acted upon.
Welcome to the world of Ruby Roses on OnlyFans. Get ready for a personalized journey filled with artistry, connection, and endless entertainment that promises to captivate you like never before.
How to Get in Touch with Ruby Roses
Eager to connect with Ruby Roses and possibly request personalized content? Hereโs how you can get in touch:
1. Follow her on OnlyFans:ย Click the 'Subscribe' button now to gain access to all her captivating content.
2. Engage through messages:ย Once subscribed, Ruby Roses will be just a message away. Feel free to introduce yourself and share your preferences for personalized content.
3. Explore FAQs:ย If you have questions about her content or services, head over to the FAQ section on her profile page. You'll find answers to common queries there.
4. Join her community:ย Ruby Roses encourages interaction and discussion with her followers. Engage in comments sections, fan groups, or social media platforms where she might be active for a more connected experience.
To ensure your message reaches Ruby Roses promptly and directly, use the messaging feature on OnlyFans to share your thoughts or any specific content requests you'd like to see.
Accessing Ruby Roses' OnlyFans for Absolutely Free: The Guide
Unlock the world of captivating content from @0nlyrubyroses without breaking your bank! Follow these simple steps to access her exclusive platform at no cost:
Step 1: Begin by visiting @0nlyrubyroses. Make sure you're ready for an array of thrilling entertainment.
Step 2: Since Ruby Roses offers her content at no subscription fee, simply sign up or log in to your account on the platform. No payment is required during this process; it's that straightforward!
Step 3: Once inside, you'll notice her vast collection of posts, photos, videos, and personalized media pieces waiting for you. Dive into the fun with no financial burden.
Step 4: Engage directly with Ruby Roses through messages or explore her content to your heart's content. With every post and piece of media, she promises quality entertainment at zero cost!
Remember, enjoying @0nlyrubyroses' exclusive content is now possible without any financial commitment. The only investment you'll make here is your time, soaking up the delightful offerings she shares with her fans.
Unpacking the Earnings of @0nlyrubyroses
The earnings of a content creator on OnlyFans can vary widely based on several factors including followers, engagement rates, and content type. While specific figures for individual creators' earnings are not typically publicly disclosed due to privacy concerns and fluctuating income sources, we can look at some general indicators that might suggest how @0nlyrubyroses could be performing.
Firstly, itโs important to note that @0nlyrubyroses offers her content for free. This decision not only makes her page appealing but also influences how she generates revenue indirectly through other methods such as affiliate marketing, sponsored posts, or by selling additional exclusive content via private messaging.
As a verified creator with impressive content diversity (three posts, five photos, and one video), itโs reasonable to assume that @0nlyrubyroses has an engaged audience. The level of engagement might play a significant role in the potential for sponsorships or affiliate opportunities which contribute to income.
The number of pieces of media on her profile (six total) highlights a strategic content management approach, likely aimed at maximizing visibility and interest among viewers. This strategy could help attract more followers, thus increasing the chance of being approached by brands interested in collaborations that pay well.
However, without detailed insights into her engagement rates or specific interaction metrics such as likes, comments, or messages sent, itโs challenging to estimate a precise amount @0nlyrubyroses might be earning indirectly. As she has been active since July 19th, 2024, her income is likely accumulating over time through various opportunities.
In conclusion, while specific earnings figures for @0nlyrubyroses may not be publicly available, considering the strategies employed by creators like her and the engagement they have managed to maintain on their platforms can offer a glimpse into potential revenue streams that might contribute to her income over time.